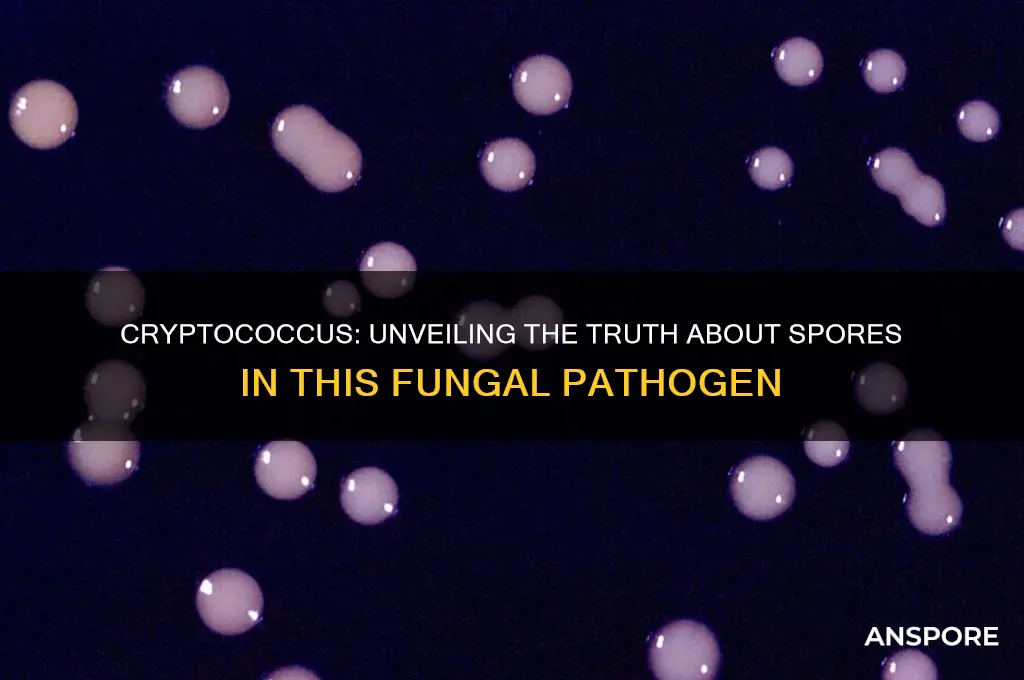
do cryptococcus have spores

Cryptococcus, a genus of fungi commonly found in the environment, particularly in bird droppings and soil, is known for its ability to cause infections in humans and animals. One of the key questions surrounding this organism is whether it produces spores, which are typically associated with fungal reproduction and dispersal. Unlike many other fungi, Cryptococcus does not form true spores such as asci or basidiospores. Instead, it reproduces through the production of yeast-like cells that bud off from the parent cell, forming a structure called a basidiospore under certain conditions, though these are not considered true spores in the traditional fungal sense. Understanding the reproductive mechanisms of Cryptococcus is crucial, as it plays a significant role in its ability to survive and spread in various environments, as well as its pathogenicity in immunocompromised individuals.
| Characteristics | Values |
|---|---|
| Do Cryptococci produce spores? | No |
| Reproductive method | Budding (asexual reproduction) |
| Cell type | Yeast-like cells |
| Capsule presence | Yes (polysaccharide capsule) |
| Pathogenicity | Opportunistic pathogen, causes cryptococcosis |
| Habitat | Found in soil, bird droppings, and decaying wood |
| Transmission | Inhalation of fungal cells |
| Spores (if any) | None; cryptococci do not form spores |
| Related fungi with spores | Other fungal species like Aspergillus and Candida produce spores, but Cryptococcus does not |
Explore related products
What You'll Learn
- Cryptococcus reproductive methods: Asexual reproduction via budding, no spores formed
- Cryptococcus dispersal mechanisms: Yeast cells spread through desiccation-resistant capsules
- Comparison with spore-forming fungi: Unlike Aspergillus or Penicillium, Cryptococcus lacks spores
- Environmental survival strategies: Capsule aids survival, not spore-based resistance
- Clinical implications of non-spore formation: No airborne spores reduce certain infection risks

Cryptococcus reproductive methods: Asexual reproduction via budding, no spores formed
Cryptococcus, a genus of fungi, reproduces asexually through a process known as budding, which sets it apart from many other fungal species that rely on spore formation. This method involves the development of a small outgrowth, or bud, on the parent cell, which eventually detaches to form a new individual. Unlike spore-producing fungi, Cryptococcus does not generate specialized cells for dispersal or survival in harsh conditions. Instead, budding allows for rapid multiplication under favorable environments, such as within a host organism or in nutrient-rich substrates. This reproductive strategy is efficient but limits the fungus's ability to withstand extreme external conditions without a protective spore structure.
Analyzing the implications of this reproductive method reveals both advantages and limitations. Budding enables Cryptococcus to quickly colonize tissues in immunocompromised hosts, such as those with HIV/AIDS, making it a significant opportunistic pathogen. For instance, *Cryptococcus neoformans* and *Cryptococcus gattii* are known to cause cryptococcal meningitis, a severe infection of the central nervous system. The absence of spores simplifies the fungus's life cycle but also means it relies heavily on consistent environmental conditions for survival. Clinically, this characteristic is crucial: antifungal treatments like amphotericin B (0.7–1.0 mg/kg/day) or fluconazole (400–800 mg/day) target actively growing cells, as dormant spore forms are not present to complicate eradication.
From a practical standpoint, understanding Cryptococcus's budding-only reproduction informs diagnostic and treatment strategies. Laboratory identification often involves observing yeast-like cells with buds under a microscope, typically stained with India ink or cultured on Sabouraud agar. Patients at risk, such as those with CD4 counts below 100 cells/μL, should undergo regular screening for cryptococcal antigen in serum or cerebrospinal fluid. Early detection is critical, as untreated cryptococcal meningitis has a mortality rate exceeding 90% within three months. Unlike spore-forming fungi, Cryptococcus does not require aerosol precautions in healthcare settings, as it does not disperse via airborne spores.
Comparatively, the absence of spores in Cryptococcus contrasts with fungi like *Aspergillus* or *Candida*, which use spores for dispersal and survival. This distinction influences both ecological niches and clinical management. For example, while *Aspergillus* spores can persist in hospital environments, Cryptococcus relies on direct transmission from environmental sources, such as pigeon droppings. In agriculture, this difference means Cryptococcus is less likely to contaminate crops via airborne spores, though it can still cause infections in plants under specific conditions. Such comparisons highlight the importance of tailoring control measures to the reproductive biology of each fungal species.
In conclusion, Cryptococcus's reliance on budding for asexual reproduction, without spore formation, shapes its pathogenicity, detection, and treatment. This method enables rapid growth in susceptible hosts but limits environmental resilience. Clinicians and researchers must consider this unique reproductive strategy when managing cryptococcal infections, emphasizing early diagnosis and targeted antifungal therapy. By focusing on these specifics, healthcare providers can improve outcomes for patients at risk, particularly in immunocompromised populations.
Using Spore with DirectX 12: Compatibility, Performance, and Setup Guide
You may want to see also

Cryptococcus dispersal mechanisms: Yeast cells spread through desiccation-resistant capsules
Cryptococcus, a genus of yeast-like fungi, lacks true spores but employs a unique survival strategy centered on its desiccation-resistant capsule. This polysaccharide-rich structure envelops the cell, enabling it to withstand harsh environmental conditions, including extreme dryness. Unlike spore-forming fungi, which shed dormant structures for dispersal, Cryptococcus relies on its encapsulated yeast cells to persist and spread. This adaptation allows it to thrive in diverse habitats, from tree excrement to human lungs, where it can cause cryptococcosis, a potentially fatal infection.
The capsule’s role in dispersal is twofold: protection and adherence. When environmental conditions deteriorate, the capsule hardens, forming a barrier against desiccation, UV radiation, and predation. This resilience permits the yeast cells to remain viable in air, soil, and water for extended periods. Upon encountering a suitable host or environment, the capsule facilitates adherence to surfaces, enhancing the likelihood of colonization. For instance, in human infections, the capsule binds to lung epithelial cells, evading immune responses and establishing infection.
Understanding this mechanism has practical implications for prevention and treatment. In healthcare settings, HEPA filters and proper ventilation can reduce airborne transmission, as encapsulated cells are more likely to remain suspended in air currents. For at-risk populations, such as immunocompromised individuals, antifungal prophylaxis with fluconazole (200–400 mg daily) may be recommended in endemic areas. Environmental control measures, like reducing pigeon droppings in urban spaces, can also limit exposure, as birds are a primary vector for Cryptococcus dispersal.
Comparatively, while spore-forming fungi like Aspergillus rely on lightweight, easily dispersed spores, Cryptococcus leverages its capsule’s durability and adhesive properties. This distinction highlights the evolutionary ingenuity of Cryptococcus in adapting to dispersal without spores. By focusing on capsule-mediated survival, researchers can develop targeted interventions, such as capsule-inhibiting drugs or immunotherapies that disrupt its protective functions. This approach underscores the importance of understanding unique microbial strategies for effective disease management.
In summary, Cryptococcus’s desiccation-resistant capsule serves as both a shield and a tool for dispersal, compensating for the absence of spores. This mechanism not only ensures its survival in diverse environments but also enhances its pathogenic potential. Practical measures, from environmental controls to targeted therapies, can mitigate risks, emphasizing the need to study such adaptations in microbial ecology and medicine. By focusing on the capsule, we gain insights into a fungus that defies conventional dispersal paradigms, offering lessons for both prevention and treatment.
Spore-Forming vs. Non-Spore-Forming Bacteria: Key Differences and Visibility
You may want to see also

Comparison with spore-forming fungi: Unlike Aspergillus or Penicillium, Cryptococcus lacks spores
Cryptococcus, a genus of yeast-like fungi, stands apart from spore-forming fungi such as Aspergillus and Penicillium due to its inability to produce spores. While Aspergillus and Penicillium rely on spores for reproduction and dispersal, Cryptococcus employs a different strategy. Instead of forming spores, Cryptococcus reproduces through budding, a process where a small daughter cell emerges from the parent cell. This fundamental difference in reproductive mechanisms has significant implications for their ecology, pathogenicity, and management in clinical and environmental settings.
From an ecological perspective, the absence of spores in Cryptococcus limits its ability to disperse over long distances compared to Aspergillus and Penicillium. Spores are lightweight and can be carried by air currents, allowing spore-forming fungi to colonize new environments rapidly. Cryptococcus, however, relies on other means of dispersal, such as water or animal vectors, which are less efficient. This distinction explains why Cryptococcus is often found in specific niches, like pigeon droppings or decaying wood, rather than being ubiquitous like some spore-forming fungi.
Clinically, the lack of spores in Cryptococcus influences its interaction with the human immune system. Spores of Aspergillus and Penicillium can act as potent allergens or triggers for respiratory conditions like asthma. In contrast, Cryptococcus primarily causes disease through the inhalation of its yeast cells, which can lead to cryptococcosis, a serious fungal infection, particularly in immunocompromised individuals. Understanding this difference is crucial for healthcare providers, as it guides diagnostic and treatment approaches. For instance, antifungal therapies targeting Cryptococcus, such as amphotericin B (initial dose: 0.7–1.0 mg/kg/day) or fluconazole (maintenance dose: 400 mg/day), focus on eliminating yeast cells rather than spores.
Practically, the absence of spores in Cryptococcus simplifies environmental control measures in healthcare settings. While spore-forming fungi require stringent air filtration systems (e.g., HEPA filters) and frequent disinfection to prevent contamination, managing Cryptococcus involves minimizing its primary sources, such as pigeon droppings near ventilation systems. For individuals at risk, practical tips include avoiding areas with bird infestations and using masks with appropriate filtration (e.g., N95) in high-risk environments.
In conclusion, the comparison of Cryptococcus with spore-forming fungi like Aspergillus and Penicillium highlights its unique biology and implications for ecology, medicine, and environmental management. Recognizing these differences enables targeted strategies to control and treat infections, underscoring the importance of understanding fungal reproductive mechanisms in both scientific and practical contexts.
How Far Can Mold Spores Travel: Unveiling Their Airborne Journey
You may want to see also
Explore related products

Environmental survival strategies: Capsule aids survival, not spore-based resistance
Cryptococcus, a genus of fungi, is known for its ability to thrive in diverse environments, from pigeon guano to human lungs. Unlike many other fungi, it does not rely on spores for survival. Instead, its primary environmental survival strategy hinges on a thick, polysaccharide capsule that surrounds the cell wall. This capsule is not merely a protective barrier; it is a dynamic tool that confers multiple advantages in harsh conditions. For instance, the capsule helps Cryptococcus evade phagocytosis by macrophages, a critical defense mechanism in mammalian hosts, by masking the fungal cell from immune recognition.
Analyzing the capsule’s composition reveals its strategic importance. Composed primarily of glucuronoxylomannan (GXM), the capsule modulates the host immune response, promoting fungal persistence. In non-host environments, such as soil or bird droppings, the capsule aids in desiccation resistance, allowing Cryptococcus to survive in dry conditions for extended periods. This contrasts sharply with spore-forming fungi like *Aspergillus* or *Clostridium*, which rely on spores to endure extreme environments. The capsule’s ability to retain moisture and protect against UV radiation underscores its role as a multifunctional survival mechanism.
From a practical standpoint, understanding the capsule’s role in environmental survival has direct implications for infection control. For example, in healthcare settings, surfaces contaminated with Cryptococcus can pose a risk, especially to immunocompromised individuals. Unlike spore-forming pathogens, which require specialized decontamination protocols, Cryptococcus can be effectively eliminated with standard disinfectants like quaternary ammonium compounds or hypochlorite solutions. However, its ability to persist in the environment necessitates rigorous cleaning practices, particularly in areas with high pigeon populations or organic debris.
Comparatively, the absence of spores in Cryptococcus simplifies its environmental management but complicates its clinical treatment. While spores are often more resistant to antifungal agents, the capsule’s immune-modulating properties make Cryptococcus infections challenging to treat. Antifungal therapies, such as amphotericin B or fluconazole, must penetrate the capsule to target the fungal cell, often requiring higher dosages (e.g., 0.7–1.0 mg/kg/day for amphotericin B) and prolonged treatment durations. This highlights the capsule’s dual role: a survival asset in the environment and a therapeutic hurdle in the host.
In conclusion, the capsule of Cryptococcus exemplifies an elegant, spore-independent survival strategy. Its ability to protect against environmental stressors and manipulate host defenses underscores its evolutionary sophistication. For clinicians and researchers, this knowledge informs both infection control measures and treatment strategies, emphasizing the need to target the capsule in therapeutic interventions. By focusing on this unique adaptation, we gain insights into the resilience of Cryptococcus and avenues to combat its persistence in both ecological and clinical contexts.
Buying Psilocybin Mushroom Spores: Legal, Safe, and Informed Choices
You may want to see also

Clinical implications of non-spore formation: No airborne spores reduce certain infection risks
Cryptococcus species, unlike many fungal pathogens, do not produce spores. This biological characteristic significantly influences their transmission dynamics and clinical implications. The absence of airborne spores means that cryptococcal infections are not spread through inhalation of fungal particles, a common route for spore-forming fungi like *Aspergillus* or *Histoplasma*. Instead, *Cryptococcus* primarily disseminates through the environment via desiccated yeast cells in bird excreta, particularly from pigeons. This distinction is crucial for understanding infection risks and implementing targeted preventive measures.
From a clinical perspective, the non-spore-forming nature of *Cryptococcus* reduces the risk of nosocomial airborne transmission in healthcare settings. Unlike spore-forming fungi, which can linger in hospital ventilation systems or dust, *Cryptococcus* requires direct or indirect contact with contaminated environmental sources. For instance, immunocompromised patients, such as those with HIV/AIDS or on immunosuppressive therapies, are more susceptible to cryptococcal infections, but the risk is primarily linked to environmental exposure rather than airborne spores. This knowledge allows healthcare providers to focus on specific infection control strategies, such as avoiding pigeon-infested areas and ensuring proper sanitation in high-risk environments.
The absence of spores also impacts diagnostic and therapeutic approaches. Since *Cryptococcus* does not produce airborne particles, sputum or respiratory samples may not always yield positive cultures, necessitating alternative diagnostic methods like cerebrospinal fluid (CSF) analysis for cryptococcal antigen in cases of meningitis. Treatment protocols, such as the use of amphotericin B (0.7–1.0 mg/kg/day) combined with fluconazole (800–1200 mg/day) for induction therapy, remain consistent, but the non-spore-forming nature underscores the importance of early detection and environmental management to prevent infection in vulnerable populations.
Comparatively, the clinical implications of non-spore formation in *Cryptococcus* contrast sharply with spore-forming fungi. For example, *Aspergillus* spores can remain viable for extended periods, increasing the risk of latent infections in immunocompromised individuals. In contrast, *Cryptococcus* requires more immediate environmental exposure, limiting its transmission potential. This difference highlights the need for tailored public health strategies, such as educating at-risk groups about avoiding pigeon droppings and ensuring proper ventilation in indoor spaces to minimize fungal burden.
In practical terms, understanding the non-spore-forming nature of *Cryptococcus* empowers clinicians and patients to take proactive steps. For immunocompromised individuals, simple measures like wearing masks in dusty environments or avoiding areas with visible bird droppings can significantly reduce infection risk. Additionally, healthcare facilities can implement environmental monitoring programs to detect and mitigate *Cryptococcus* contamination. By focusing on these specific risks, rather than generic airborne precautions, healthcare providers can optimize infection prevention and management strategies for this unique fungal pathogen.
Does Halo of Spores Affect Multiple Enemies Simultaneously? A Detailed Analysis
You may want to see also
Frequently asked questions
Yes, Cryptococcus species produce spores, specifically basidiospores, as part of their reproductive cycle.
Cryptococcus fungi form basidiospores, which are produced on a specialized structure called a basidium during sexual reproduction.
Yes, Cryptococcus spores are typically airborne and can be found in the environment, particularly in bird droppings and soil.
Cryptococcus spores can cause infection when inhaled into the lungs, where they may disseminate to other organs, particularly in immunocompromised individuals.
Yes, Cryptococcus spores are resilient and can survive in harsh environmental conditions, including dry and nutrient-poor environments, contributing to their widespread distribution.































